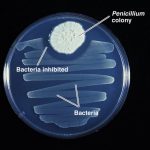
Penicillin – Wonderstuff

Tag: health
Good News for Bibliophiles – Reading is Good...
Oct 17, 2017 | General Interest, Literature, Trivia |
Health and Safety Gone Mad
May 15, 2015 | Humour |
What can you eat that uses up more calories than i...
Mar 3, 2015 | Food & Drink, Science |
How do Immunization Vaccines Work ?
Jan 30, 2015 | General Interest, Science |
Is eating fish really good for your brain?
Jan 13, 2015 | Food & Drink, General Interest |
All
LatestLaughter, The Best Medicine – Genuine Comments made by Doctors in their Patients Notes
Jun 10, 2014 | Humour |
They say “laughter is the best medicine” so what better than a chortle over a...
-

Laughter really IS the best medicine
Feb 21, 2014 | Science |
-
Penicillin – Wonderstuff
Jun 1, 2012 | Science |

